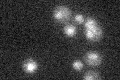
YBR223C

View description
Tyrosyl-DNA Phosphodiesterase I, hydrolyzes 3' and 5'-phosphotyrosyl bonds, involved in the repair of DNA lesions created by topoisomerase I and topoisomerase II; mutations in human homolog result in the neurodegenerative disease SCANI
Localization:
Intensity:
Fold change:
Significance:
-
C’ GFP library in SD

below threshold14.6 -
N' NOP1pr-GFP in SD

punctate,nucleus64.7321 -
N' TEF2pr-mCherry in SD

nucleus74.2195 -
N' NATIVEpr-GFP in SD

ambiguous,ER20.6684 -
N' TEF2pr-VC and Cyto-VN in SD

nucleus28.615 -
C’ GFP library in SD+DTT

cytosol19.481.33No -
C’ GFP library in SD+H2O2

cytosol14.260.97No -
C’ GFP library in Starvation Media
cytosol18.261.24No -
C’ GFP library on the background of Pup2-DaMP

below threshold -
C’ GFP library on the background of CCT mutant

below threshold17.28741.18317No
